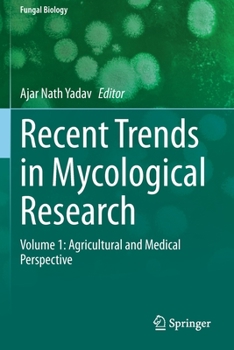

Recent Trends in Mycological Research: Volume 1: Agricultural and Medical Perspective
Select Format
Select Condition 
Book Overview
Fungi range from being microscopic, single-celled yeasts to multicellular and heterotrophic in nature. Fungal communities have been found in vast ranges of environmental conditions. They can be associated with plants epiphytically, endophytically, or rhizospherically. Extreme environments represent unique ecosystems that harbor novel biodiversity of fungal communities.
Interest in the exploration of fungal diversity has been spurred by the fact that fungi perform numerous functions integral in sustaining the biosphere, ranging from nutrient cycling to environmental detoxification, which involves processes like augmentation, supplementation, and recycling of plant nutrients - a particularly important process in sustainable agriculture. Fungal communities from natural and extreme habitats help promote plant growth, enhance crop yield, and enhance soil fertility via direct or indirect plant growth promoting (PGP) mechanisms of solubilization of phosphorus, potassium, and zinc, production of ammonia, hydrogen cyanides, phytohormones, Fe-chelating compounds, extracellular hydrolytic enzymes, and bioactive secondary metabolites. These PGP fungi could be used as biofertilizers, bioinoculants, and biocontrol agents in place of chemical fertilizers and pesticides in eco-friendly manners for sustainable agriculture and environments.
Along with agricultural applications, medically important fungi play a significant role for human health. Fungal communities are useful for sustainable environments as they are used for bioremediation which is the use of microorganisms' metabolism to degrade waste contaminants (sewage, domestic, and industrial effluents) into non-toxic or less toxic materials by natural biological processes. Fungi could be used as mycoremediation for the future of environmental sustainability. Fungi and fungal products have the biochemical and ecological capability to degrade environmental organic chemicals and to decrease the risk associated with metals, semi-metals, and noble metals either by chemical modification or by manipulating chemical bioavailability.
The two volumes of Recent Trends in Mycological Research aim to provide an understanding of fungal communities from diverse environmental habitats and their potential applications in agriculture, medical, environments and industry. The books are useful to scientists, researchers, and students involved in microbiology, biotechnology, agriculture, molecular biology, environmental biology and related subjects.
Interest in the exploration of fungal diversity has been spurred by the fact that fungi perform numerous functions integral in sustaining the biosphere, ranging from nutrient cycling to environmental detoxification, which involves processes like augmentation, supplementation, and recycling of plant nutrients - a particularly important process in sustainable agriculture. Fungal communities from natural and extreme habitats help promote plant growth, enhance crop yield, and enhance soil fertility via direct or indirect plant growth promoting (PGP) mechanisms of solubilization of phosphorus, potassium, and zinc, production of ammonia, hydrogen cyanides, phytohormones, Fe-chelating compounds, extracellular hydrolytic enzymes, and bioactive secondary metabolites. These PGP fungi could be used as biofertilizers, bioinoculants, and biocontrol agents in place of chemical fertilizers and pesticides in eco-friendly manners for sustainable agriculture and environments.
Along with agricultural applications, medically important fungi play a significant role for human health. Fungal communities are useful for sustainable environments as they are used for bioremediation which is the use of microorganisms' metabolism to degrade waste contaminants (sewage, domestic, and industrial effluents) into non-toxic or less toxic materials by natural biological processes. Fungi could be used as mycoremediation for the future of environmental sustainability. Fungi and fungal products have the biochemical and ecological capability to degrade environmental organic chemicals and to decrease the risk associated with metals, semi-metals, and noble metals either by chemical modification or by manipulating chemical bioavailability.
The two volumes of Recent Trends in Mycological Research aim to provide an understanding of fungal communities from diverse environmental habitats and their potential applications in agriculture, medical, environments and industry. The books are useful to scientists, researchers, and students involved in microbiology, biotechnology, agriculture, molecular biology, environmental biology and related subjects.
Format:Paperback
Language:English
ISBN:3030606619
ISBN13:9783030606619
Release Date:February 2022
Publisher:Springer
Length:498 Pages
Weight:1.59 lbs.
Dimensions:1.1" x 6.1" x 9.2"
Related Subjects
Engineering Science Science & Math Science & Scientists Science & Technology TechnologyCustomer Reviews
0 rating